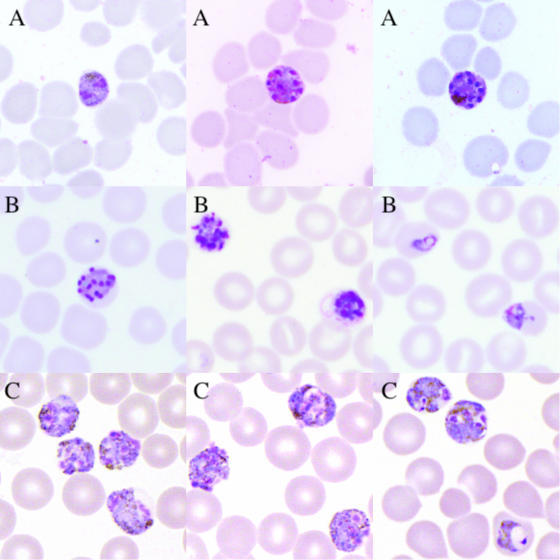

Những khó khăn và thách thức trong phòng chống và loại trừ sốt rét do Plasmodium malariae
·Giai đoạn tiềm tàng (Prepatent period) và Giai đoạn ủ bệnh (Incubation period) kéo dài
Chỉ một số ít các báo cáo về sự lây truyền P. malariaeđã xác định được thời gian của gian đoạn tiềm tàng. Giai đoạn tiềm tàng được định nghĩa là thời gian cho đến ngày đầu tiên ký sinh trùng được phát hiện trên giọt máu dày khi soi lam sốt rét. Sau đây là một số tổng hợp về các giai đoạn này của P.malariae:
Tác giả Shute và Maryon đã báo cáo thời gian tiềm tàng ngắn nhất là 16 ngày đối với chủng Tây Phi. Boyd và Stratman-Thomasđã báo cáo thời gian tiềm tàng là 27,32 và 37 ngày đối với hai chủng khác nhau và Mer đã thực hiện truyền một chủng Palestine cho ba bệnh nhân, trong đó thời gian tiềm tàng là 26, 28 và 31 ngày. Giai đoạn tiềm tàng là 23 và 26 ngày đã được de Buckbáo cáo đối với bốn bệnh nhân bị nhiễm chủng Vienna. Tác giả Boyd và Stratman-Thomasđã báo cáo thời gian tiềm tàng là 28 và 40 ngày. Marotta và Sandicchiđã báo cáo thời gian ủ bệnh (số ngày cho đến khi xuất hiện triệu chứng đầu tiên) là 23 và 29 ngày ở hai bệnh nhân. Boyd cũng đã báo cáo về ba chủng khác nhau có thời gian ủ bệnh dao động từ 28 đến 37 ngày. Siddonsbáo cáo thời gian tiềm tàng là 30 ngày, và Young và Burgessbáo cáo thời gian tiềm tàng là 29 và 59 ngày. Mackerras và Ercoleđã báo cáo khoảng thời gian này là 24 ngày đối với chủng Melanesian, và Kitchenđã báo cáo thời gian tiềm tàng trung bình là 32,2 ngày (dao động từ 27-37 ngày) đối với các chủng P. malariae ở Mỹ. Tác giả Young và Burgessđã cho thấy thời gian tiềm tàng là 33 và 36 ngày. Ciuca và cộng sựđã báo cáo thời gian tiềm tàng khi nhiễm chủng VS Romania là18 đến 25 ngày. Lupascu và cộng sựđã báo cáo thời gian ủ bệnh từ 18 đến 19 ngày đối với chủng VS; ở bốn bệnh nhân bổ sung, thời gian chuẩn bị dao động từ 21 đến 30 ngày. Trong các nghiên cứu lây truyền với một chủng ở Nigeria có sự tham gia của bốn tình nguyện viên, thời gian tiềm tàngdao động từ 24 đến 33 ngày.
Với những dữ liệu này cho thấy, có một khoảng thời gian dài trong giai đoạn tiềm tàng cũng như giai đoạn ủ bệnh của bệnh ở P. malariae (16 đến 59 ngày). Đây cũng chính là một khó khăn cho công tác phòng chống và loại trừ sốt rét hiện này, một trong những khó khăn cho công tác giám sát dịch tễ sốt rét đó làđiều tra tiền sử đi lại của bệnh nhân để có thể xác định chính xác nơi nghi ngờ mắc, vì thường cán bộ y tế sẽ dựa chủ yếu vào cột mốc điều tra tiền sử đi lại trong vòng 14 ngày trước đó, đây là mốc thời gian phù hợp hơn cho nhưng loài phổ biến như P.falciparum, P.vivax. Vì vậy với các trường hợp sốt rét do P.malariae cần phải mở rộng cột mốc thời gian tiền sử đi lại của bệnh nhân (>14 ngày) để có thể xác định chính xác nơi nghi ngờ mắc, từ đó định hướng các can thiệpđúng với địa điểm có lan truyền sốt rét, nâng cao hiệu quả điều tra và can thiệp các ổ bệnh sốt rét hiện này tại các địa phương.
·Nhiễm KSTSR mật độ thấp
Ở giai đoạn gần tiến tới LTSR, có sự thay đổi trong xu hướng lây nhiễm sốt rét với tỷ lệ sốt rét do Plasmodium falciparum giảm và tỷ lệ sốt rét do các loài KSTSR khác tăng lên. Đây là mối lo ngại vì các chiến lược loại trừsốt rét hiện nay đang tập trung vào nhiễm P. falciparum và Plasmodium vivax, và các biện pháp kiểm soát hiện tại có thể không phù hợp để giảm các bệnh nhiễm trùng không phải P.falciparum và P.vivax. Số lượng ký sinh trùng tối đa ở bệnh nhân nhiễm P.malariae thường thấp so vớibệnh nhân nhiễm P. falciparum hoặc P. vivax. Điều này có thể do một số yếu tố:
(i)Số lượng merozoite được tạo ra trên mỗi chu kỳ hồng cầu thấp hơn.
(ii)Chu kỳ phát triển kéo dài 72 giờ so với chu kỳ 48 giờ của P. falciparum và P. vivax
(iii)Ký sinh trùng thường phát triển trong các hồng cầu già.
(iv)Sự kết hợp của các yếu tố này đã làm cho người bệnh có thể phát triển khả năng miễn dịch sớm hơn.
Một nghiên cứu của McKenzie FE và cộng sựkhi phân tích 69 bệnh nhân, số lượng ký sinh trùng tối đa dao động từ 1.648/μl đến 49.680/μl, với số lượng trung bình là 8.875/μl (10.000/μl = 0,25% số hồng cầu bị nhiễm bệnh).Nhiễm trùng với mật độ KSTSR thấp, đặc biệt dưới ngưỡng phát hiện của kính hiển vi là một thách thức lớn trong việc loại trừ sốt rét vì một số trường hợp nhiễm KSTSR mà không có bất kỳ triệu chứng nàovẫn là nguồn lây truyềnsốt rét cho cộng đồng. Ở những vùng lan truyền thấp, kiểm tra bằng kính hiển vi sẽ bỏ sót một tỷ lệ đáng kể ký sinh trùng do nhiễm trùng dưới kính hiển vi tồn tại lâu hơn do không có phương pháp điều trị thích hợp.Việc phân biệt P. malariae với P. falciparum và P. ovale với P. vivax bằng soi kính hiển vi có thể là thách thức. Tỷ lệ ký sinh trùng thấp, thường được quan sát thấy đối với P. malariae và P. ovale, vì vậy thường kỹ thuật viên sẽ soi bằng giọt dày trên lam máu; tuy nhiên, kỹ thuật này làm mất đi nhiều đặc điểm phân biệt của hồng cầu bị nhiễm bệnh.Do đó, ở các vùng lưu hành P. falciparum và/hoặc P. vivax chiếm ưu thế, thì P. malariae và P. ovale thường bị bỏ sót. Ngoài ra, RDTs hiện đang được sử dụng như một công cụ chẩn đoán quan trọng ở nhiều cơ sở y tế, đã cho thấy hiệu quả kém trong việc phát hiện P. malariae và P. ovale spp.Vì vậy, với khả năng gây bệnh kết hợp với việc chẩn đoán không đúng bệnh sốt rét (không phải do P. falciparum) ở nhiều nơi, làm cho gánh nặng bệnh tật toàn cầu do P. malariae và P. ovale spp. phần lớn bị đánh giá thấp. Để chẩn đoán và ước tính chính xác hơn về gánh nặng bệnh tật do nhiễm trùng P. malariae và P. ovale, cần có các phương pháp chẩn đoán nhạy cảm hơn.
·Hình thể phát triển trong hồng cầu khó phân biệt với loài khác
Giai đoạn đầu tiên xuất hiện trong máu là giai đoạn thể nhẫn được hình thành do sự xâm nhập của các merozoite được giải phóng khi thể phân liệt ở giai đoạn gan bị vỡ. Theo mô tả của Coatney và cộng sự, chúng phát triển chậm nhưng sớm chiếm 1/4 đến 1/3 tế bào hồng cầu bị ký sinh. Sắc tố tăng nhanh và ký sinh trùng đang phát triển một nửa có thể có từ 30 đến 50 hạt đen tuyền. Khi ký sinh trùng phát triển, nó có nhiều hình dạng khác nhau và thường trải dài khắp tế bào chủ để tạo thành các dải băng trong nhiễm P.malariae. Đây thường được coi là hình ảnh đặc trưng để chẩn đoán, mặc dù đôi khi chúng được nhìn thấy ở các loài khác. Tế bào chủ không to ra khi ký sinh trùng phát triển để lấp đầy hồng cầu bị nhiễm bệnh.
Tại Thái Lan và Malaysia, người ta đã chứng minh rằng nhiễm ký sinh trùng sốt rétPlasmodium knowlesi ở người đã bị chẩn đoán nhầm là nhiễm P. malariae.Việc định dạng đã được xác nhận bằng PCR. Vì vậy, kiểm tra bằng kính hiển vi cẩn thận có thể không đủ để chẩn đoán trong một số trường hợp mà ký sinh trùng sốt rét ở khỉ như P. knowlesi hoặc P. inui có thể truyền sang người. Ở các khu vực Nam Mỹ nơi con người và khỉ cùng sinh sống, không thể phân biệt nhiễm trùng P. malariae với nhiễm trùng P. brasilianum vì trên thực tế, chúng có thể là một và giống nhau.

Hình 2. Các giai đoạn phát triển của P. knowlesi trong hồng cầu người
Nguồn: Jongwutiwes S, Putaporntip C, Iwasaki T, Sata T, Kanbara H. Naturally acquired
Plasmodium knowlesi malaria in human, Thailand. Emerg Infect Dis. 2004 Dec;10(12):2211-3. doi: 10.3201/eid1012.040293. PMID: 15663864; PMCID: PMC3323387.
Một loại ký sinh trùng phức tạp khác có chu kỳ phát triển 72 giờ trong máu của vật chủ linh trưởng là Plasmodium inui. Ký sinh trùng này cũng có thể lây truyền qua thực nghiệm sang người. Việc lây truyền như vậy có xảy ra trong tự nhiên hay không vẫn chưa được chứng minh. Tuy nhiên, người ta thường phát hiện khỉ bị nhiễm P. inui ở gần con người và nhiều véc tơ khác nhau có khả năng truyền ký sinh trùng sang người. Về mặt hình thái, sẽ rất khó để phân biệt các trường hợp nhiễm ký sinh trùng sốt rét ở khỉ như P. knowlesi và P. inui với những trường hợp nhiễm P.malariae, đặc biệt nếu dựa vào chẩn đoán bằng giọt máu dày trên lam máu khi soi bằng kính hiển vi thông thường.
Hình 3. Giai đoạn phân liệt trong hồng cầu của P. malariae(A),P. knowlesi(B) và P. inui(C)
Nguồn: Collins WE, Jeffery GM. Plasmodium malariae: parasite and disease. Clin Microbiol Rev. 2007 Oct;
20(4):579-92. doi: 10.1128/CMR.00027-07. PMID: 17934075; PMCID: PMC2176047.
·Plasmodium malariae gây tình trạng nhiễm trùng kéo dài và tái phát (Recrudescence)
McKenzie FE và cộng sựkhi phân tích đặc điểm KSTSR của bệnh nhân P.malariae cho thấy, một số bệnh nhân có thời gian nhiễm ký sinh trùng kéo dài và thời gian kéo dài khi số lượng ký sinh trùng >1.000/μl. Những bệnh nhân này có trung bình 50,5 ngày với số lượng ký sinh trùng >1.000/μl. Khi số lượng ký sinh trùng ở những bệnh nhân này được tính trung bình trong 40 ngày đầu tiên, thì là số lượng ký sinh trùng đạt đỉnh điểm vào khoảng 2 tuần và sau đó duy trì tương đối ổn định. Số lượng ký sinh trùng trung bình thực sự khônggiảm cho đến khoảng 60 ngày hoặc lâu hơn sau khi ký sinh trùng xuất hiện.
Plasmodiummalariae không tái phát xa (relapse)vì không có thể ngủ ởgan. Tuy nhiên, ký sinh trùng ở giai đoạn máu vẫn tồn tại trong thời giandài, nên có thể tái hoạt động trở lại sau nhiều thập kỷ và tồn tại trong cơ thể dưới dạng nhiễm trùng không có triệu chứng. Hơn nữa, chu kỳhồng cầu kéo dài 72 giờ của nó có thể khiến loài này trốn tránh việc tiếp xúc với thuốc chống sốt rét. Các nghiên cứu ở Ghana, Uganda và Indonesia đã báo cáo sự tái phát của P. malariae sau 3 ngày điều trị bằng ACT, cho thấy rằng phương pháp điều trị phổ biến cho bệnh sốt rét có thể không đủ phù hợp để hỗ trợ loại trừ bệnh sốt rét ở người, đặc biệt là đối với P. malariae.P. malariae có thể có những đặc điểm sinh học độc đáokhiến ký sinh trùng về bản chất ít nhạy cảm hơn với một số loại thuốc và đặc biệt với vòng đời 72 giờ thì khả năng sống sót sau quá trình 3 ngày với các thuốc có thời gian bán hủy ngắn nhưArtemisinin có nhiều khả năng xảy ra hơn. Đây là một lời giải thích cho việc thuốc điều trị không có khả năng loại bỏ hoàn toàn tất cả các bệnh nhiễm trùng, giai đoạn phân liệtkéo dài hơn từ 10-16 ngày ở giai đoạn gancũng có thể giúp tránh được việc điều trị dự phòng.

Hình 4. Số lượng KSTSR trung bình trong 40 ngày của 69 bệnh nhân nhiễm P.malariae
Nguồn: McKenzie FE, Jeffery GM, Collins WE. Plasmodium malariae blood-stage dynamics. J Parasitol. 2001 Jun;
87(3):626-37. doi: 10.1645/0022-3395(2001)087[0626:PMBSD]2.0.CO;2. PMID: 11426728; PMCID: PMC2483342.
Đã có nhiều báo cáo về những trường hợp bệnh nhân sau khi rời khỏi vùng sốt rét lưu hành hoặc trường hợp khi hiến máu mà người nhận bị nhiễm trùng hoặc bị căng thẳng, tình trạng nhiễm trùng của họ đã tái phát sau nhiều năm không hoạt động. Ví dụ, Collins và cộng sự đã báo cáo về một trường hợp truyền máu trong đó người hiến có thể đã bị nhiễm P. malariae ở Trung Quốc 50 năm trước. Tác giả Vinetz và các cộng sựbáo cáo một trường hợp nhiễm trùng mắc phải ở Hy Lạp hơn 40 năm (và có thể lên đến 70 năm) trước khi cắt lách và chẩn đoán sau đó. Bởi vì hầu hết tất cả các bệnh nhiễm trùng lâu dài này đều được phát hiện sau khi truyền máu, người ta tin rằng ký sinh trùng vẫn tồn tại trong máu với mật độ rất thấp. Với những trường hợp này sẽ gây rất nhiều khó khăn trong việc kiểm soát và duy trì thành quả loại trừ sốt rét. Khi tái phát trở lại, các trường hợp bệnh không được phát hiện chủ động, đây sẽ là một nguồn lây nhiễm tiềm tàng tại các địa phương và sốt rét có thể bùng phát trở lại bất kể lúc nào nếu không được can thiệp kịp thời.
Bảng 3. Tổng hợp một số trường hợp tái phát (Recrudescence) do P.malariae
Tác giả/Năm | Tuổi/Giới | Quốc gia ghi nhận THB | Loài KSTSR | PCR | Khoảng thời gian giữa | Điều trị |
Shute/1944 | 26/Nữ | Ấn Độ | P. malariae (KHV) | - | 21 năm | Mepacrine |
Spitler/1948 | 69/Nam | Ý | P. malariae(KHV) | - | 36 năm | Quinine |
Lentini/1955 | 70/Nữ | Ý | P. malariae (KHV) | - | 45 năm | Quinine |
Creyx/1955 | 56/Nữ | Macedonia | P. malariae (KHV) | - | 32 năm | Quinine, plasmoquine |
Duggan and Shute/1961 | 42/Nam | Myanmar | P. malariae (KHV) | - | 13 năm | Primaquine |
Guazzi/1963 | 63/Nữ | Ý | P. malariae (KHV) | - | 53 năm | Không báo cáo |
Tsuchida/1982 | 63/Nam | Papua New Guinea | P. malariae (KHV) | - | 36 năm | Sulfa-pyrimethamine, primaquine |
Hess/1993 | 46/Nữ | Kenya | P. malariae (KHV) | - | 106 ngày | Halofantrine |
Vinetz/1998 | 72/Nữ | Greece | P. malariae (PCR) | Có | 40-70 Năm | Chloroquine |
Chadre/2000 | 70/Nam | Trinidad | P. malariae (KHV) | - | 33 năm; có thể 65 năm | Chloroquine + primaquine |
Skoutelis/2000 | 60/Nữ | Greece | P. malariae (KHV) | - | 45 năm | Chloroquine |
Morovic/2003 | 61/Nam | Croatia | P. malariae (KHV) | - | 35 năm | Chloroquine |
Chim/2004 | 66/Nữ | Trung Quốc | P. malariae (KHV) | - | 55 năm | Chloroquine |
Muller-Stover/2008 | 34/Nam | Nigeria | P. malariae (KHV; PCR) | Có | 14 tuần | Atovaquone/proguanil |
Smith/2011 | 59/Nam | Uganda | P. malariae (KHV) | - | 47 ngày | Chloroquine |
Hedelius/2011 | 34/Nam | Nigeria | P. malariae (KHV; PCR) | Có | 14 năm | Atovaquone/proguanil |
Franken/2012 | 38/Nữ | Kenya | P. malariae (KHV; PCR) | Có | 4 tháng | Chloroquine |
Hong/2012 | 23/Nữ | Ghana | P. malariae (KHV; PCR) | Có | 1 tháng | Chloroquine/Mefloquine |
Liang/2013 | 20/Nữ | Uganda | P. malariae (KHV; PCR) | Có | 8 tuần | Chloroquine/Atovaquone-proguanil |
Kugasia/2014 | 65/Nam | Sierra Leone | P. malariae(Ban đầu xác định nhầm P. falciparum) | - | 25 tháng | Quinine + clindamycin/Chloroquine |
Visser/2016 | Không rõ/Nam | Uganda | P. malariae (KHV; PCR) | - | 2 tháng | Chloroquine |
Rutledge/2017 | 31/Nam | Uganda | P. malariae (KHV; PCR) | Có | 52 ngày | Artemether/lumefantrine/Hydroxychloroquine + primaquine |
Islam/2018 | 23 tháng/Nam | Liberia | P. malariae (KHV; PCR) | Có | 4 tháng | Chloroquin/Atovaquone–proguanil |
Nguồn: Grande R, Antinori S, Meroni L, Menegon M, Severini C. A case of Plasmodium malariae recurrence: recrudescence or reinfection? Malar J. 2019 May 14;18(1):169. doi: 10.1186/s12936-019-2806-y. PMID: 31088460; PMCID: PMC6515619.
( Còn nữa) à Tiếp theo Phần 3